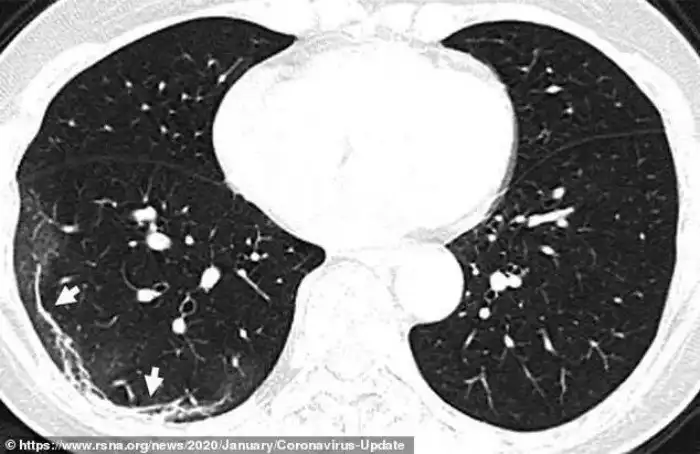

Рентген показал, что коронавирус делает с человеческими легкими
Рентгенограммы и томограммы легких 44-летнего китайского пациента, умершего от коронавируса, демонстрируют, как вирус разрушает легочную ткань. По утверждениям медиков, повреждения похожи на те, что обнаруживались в легких жертв атипичной пневмонии и ближневосточного респираторного синдрома.
Рентгеновские снимки и томограммы легких 44-летнего пациента, умершего от коронавируса, были представлены китайскими врачами. Они дают подробную картину того, как вирус разрушает легкие человека. На снимках видны белые пятна в нижних отделах легких. Медики называют их "субплевральными уплотнениями по типу матового стекла". В этих областях воздушные пузырьки легких частично заполнены содержимым. Похожие поражения наблюдались также у пациентов с атипичной пневмонией и ближневосточным респираторным синдромом.
Умерший 44-летний мужчина из Китая жил в Ухани и работал на местном рынке морепродуктов, который, вероятно, стал источником нового вируса. Он был госпитализирован 25 декабря 2019 года после двух недель болезни. Врачи диагностировали у него пневмонию и острый респираторный дистресс синдром. Несмотря на лечение, он умер неделю спустя. Субплевральные уплотнения видны в его легких очень отчетливо. На снимках видно, как легкие со временем, от снимка А до снимка F, все сильнее заполняются жидкостью. Компьютерная томограмма легких 54-летней женщины, подхватившей коронавирус во время поездки в Ухань, показывает схожую картину.
Это - снимки 54-летней женщины, у которой по возвращении из Ухани была диагностировала сильная вирусная пневмония. В ходе лечения врачи давали ей кислород и антибиотики.
Это - снимок легких 45-летней женщины из Сычуани, протестированной после возвращения из Японии и диагностированной как носительница вируса. На снимке видно некоторое количество аналогичных образований, но здесь они сосредоточены в верхней доле левого легкого.
Таким образом, утверждают медики, вирус опасен, прежде всего, разрушительным воздействием на легкие. Коварство вируса, прежде всего, заключается в долгом скрытом периоде заболевания, который длится 2 недели. Причем в этот период обнаружить вирус в организме заболевшего стандартными тестами, основанными на изучении слюны, слизи или мокроты, невозможно, - они эффективны лишь после того, как проявления болезни уже начались.
На сегодняшний день эпидемия коронавируса в Китае пошла на спад. Сильнее всего она проявляет себя в Италии, где зарегистрировано 12462 заболевших и 827 умерших от вируса.